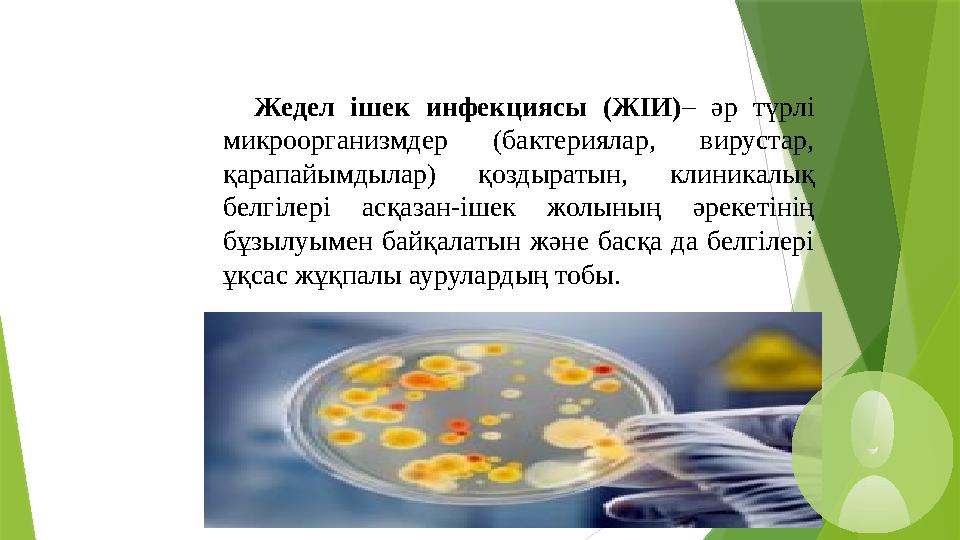
Жедел ішек инфекциясы (ЖІИ)– әр түрлі микроорганизмдер (бактериялар, вирустар, қарапайымдылар) қоздыратын, клиникалық бе

Жұқпалы аурулардың алдын алу және емдеу шаралары.


#1 слайд
ҚАЗАҚСТАН РЕСПУБЛИКАСЫ ДЕНСАУЛЫҚ САҚТАУ МИНИСТРЛІГІ
АЛМАТЫ ҚАЛАСЫ ҚОҒАМДЫҚ ДЕНСАУЛЫҚ САҚТАУ БАСҚАРМАСЫНЫҢ
ШЖҚ «ЖОҒАРЫ МЕДИЦИНАЛЫҚ КОЛЛЕДЖІ» КМК
«Арнайы пәндер» ЦӘК №4
Микробиология пәнінің
оқытушысы:
Есенжолова Мақпал
Алдиярқызы
1 слайд
ҚАЗАҚСТАН РЕСПУБЛИКАСЫ ДЕНСАУЛЫҚ САҚТАУ МИНИСТРЛІГІ АЛМАТЫ ҚАЛАСЫ ҚОҒАМДЫҚ ДЕНСАУЛЫҚ САҚТАУ БАСҚАРМАСЫНЫҢ ШЖҚ «ЖОҒАРЫ МЕДИЦИНАЛЫҚ КОЛЛЕДЖІ» КМК «Арнайы пәндер» ЦӘК №4 Микробиология пәнінің оқытушысы: Есенжолова Мақпал Алдиярқызы

#2 слайд
ТАҚЫРЫП :
ЖҰҚПАЛЫ
АУРУЛАРДЫҢ
АЛДЫН АЛУ ЖӘНЕ
ЕМДЕУ ШАРАЛАРЫ.
2 слайд
ТАҚЫРЫП : ЖҰҚПАЛЫ АУРУЛАРДЫҢ АЛДЫН АЛУ ЖӘНЕ ЕМДЕУ ШАРАЛАРЫ.

#3 слайд
Жұқпалы ауру
Инфекция – микроорганизм мен
потогендік микробтардың
әрекеттесуіндегі эволюциялық
қалыптасқан биологиялық
процестер комплексінің даму
барысындағы қағыну күйі.
Инфекция қоздырғышы
микробтардың енуі өрбуі және
тіршілік етуі микроорганизмнің
қорғаныс – бейімделу
реакциясының тууына себепкер
болады.
3 слайд
Жұқпалы ауру Инфекция – микроорганизм мен потогендік микробтардың әрекеттесуіндегі эволюциялық қалыптасқан биологиялық процестер комплексінің даму барысындағы қағыну күйі. Инфекция қоздырғышы микробтардың енуі өрбуі және тіршілік етуі микроорганизмнің қорғаныс – бейімделу реакциясының тууына себепкер болады.

#4 слайд
Ағзада қоздырғыштың
орналасуы мен жұқпаның
берілу механизміне
байланысты жұқпалы аурулар
ішек
жұқпасы
тыныс алу
қан
жұқпасы
сыртқы
қабат
жолдарын
ың
жұқпасы
4 слайд
Ағзада қоздырғыштың орналасуы мен жұқпаның берілу механизміне байланысты жұқпалы аурулар ішек жұқпасы тыныс алу қан жұқпасы сыртқы қабат жолдарын ың жұқпасы

#5 слайд
Ішек аурулары (мысалы А-гепатиті) вирус ас қорыту жолдарына ауыздан кіріп, ішектен
нәжіспен бірге шығады.
Тыныс жолдары ауруында шырышты қабықтар зақымданады және организмге вирус:
ауамен кіреді.
Қан немесе трансмиссивті аурулар (әртүрлі энцефаломиелиттер, гемаррагиялық безгектер)
аурудан сау адамға және жануарларға қан; сорғыш насекомдар арқылы беріледі, кейде
қосалқы көмекшілері болады, көбінесе табиғи-ошақты болып келеді.
Сыртқы қабықтардың аурулары (құтыру, аусыл, делбе) жанасудан, қарым-қатынаста
болудан тарайды. Вирустардьң организмде өсіп-өну және шоғырлану ерекшеліктеріне сай
оларды ошақты және жалпы деп бөледі.
5 слайд
Ішек аурулары (мысалы А-гепатиті) вирус ас қорыту жолдарына ауыздан кіріп, ішектен нәжіспен бірге шығады. Тыныс жолдары ауруында шырышты қабықтар зақымданады және организмге вирус: ауамен кіреді. Қан немесе трансмиссивті аурулар (әртүрлі энцефаломиелиттер, гемаррагиялық безгектер) аурудан сау адамға және жануарларға қан; сорғыш насекомдар арқылы беріледі, кейде қосалқы көмекшілері болады, көбінесе табиғи-ошақты болып келеді. Сыртқы қабықтардың аурулары (құтыру, аусыл, делбе) жанасудан, қарым-қатынаста болудан тарайды. Вирустардьң организмде өсіп-өну және шоғырлану ерекшеліктеріне сай оларды ошақты және жалпы деп бөледі.

#6 слайд
Жұқпалы
аурулар
пайда
болуының
үш
факторы
бар
ауру
қоздырғышы
(микроб)
қабылдауш
ы сезімтал
организм
сыртқы
орта
6 слайд
Жұқпалы аурулар пайда болуының үш факторы бар ауру қоздырғышы (микроб) қабылдауш ы сезімтал организм сыртқы орта

#7 слайд
Тыныс алу жолдарының жұқпасы
Тұмау – бұл кез келген адамның жұқтыруы мүмкін
жұқпалы ауруы. Тұмау тиген адамның қасындағы
адамдардың аңқасына енген вирустұмаудың
қоздырғышыболып табылады. Адамның көбі
тұмаумен бірнеше күн ғана ауырады, бірақ
кейбіреулердің жағдайлары одан да күрт нашарлауы
мүмкін,өлімге дейін әкелетін аурудың ауыр ағымы
болуы ықтимал.
7 слайд
Тыныс алу жолдарының жұқпасы Тұмау – бұл кез келген адамның жұқтыруы мүмкін жұқпалы ауруы. Тұмау тиген адамның қасындағы адамдардың аңқасына енген вирустұмаудың қоздырғышыболып табылады. Адамның көбі тұмаумен бірнеше күн ғана ауырады, бірақ кейбіреулердің жағдайлары одан да күрт нашарлауы мүмкін,өлімге дейін әкелетін аурудың ауыр ағымы болуы ықтимал.

#8 слайд
Таралуы
Бір мезгілде бір болыс, өлке, тіпті бүкіл
жер жүзі адамдарының жаппай ауруы
мүмкін. Бір ауырған адам бір-екі жылға
дейін қайтып тұмаумен ауырмайды. Тұмау
салқын кезде жиі, ыстықта сирек кездеседі.
Кейде адамға суық тиіп, тыныс жолының
жоғарғы бөліктері қабынып, оның тұмауға
ұқсауы да мүмкін. Бірақ бұл тұмау емес. Ол
салқын тигенде мұрын, көмей,
жұтқыншақтарды жайлайтын басқа
микробтардың әрекеті. Тұмау вирусы күн
сәулесіне және зарарсыздандырғыштар (
хлор, қышқылдар,спирт және т.б.) әсерінен
тез қырылады.
8 слайд
Таралуы Бір мезгілде бір болыс, өлке, тіпті бүкіл жер жүзі адамдарының жаппай ауруы мүмкін. Бір ауырған адам бір-екі жылға дейін қайтып тұмаумен ауырмайды. Тұмау салқын кезде жиі, ыстықта сирек кездеседі. Кейде адамға суық тиіп, тыныс жолының жоғарғы бөліктері қабынып, оның тұмауға ұқсауы да мүмкін. Бірақ бұл тұмау емес. Ол салқын тигенде мұрын, көмей, жұтқыншақтарды жайлайтын басқа микробтардың әрекеті. Тұмау вирусы күн сәулесіне және зарарсыздандырғыштар ( хлор, қышқылдар,спирт және т.б.) әсерінен тез қырылады.

#9 слайд
Грипп вирустары — екі туыстасқа
бөлінетін (А және В вирустар тобы),
ортомиксовирустар тұқымдастығына
кіреді. А туыстыққа 14 түрлі
гемагглютининдері және 10 түрлі
нейраминидазалары бар вируcтар
кіреді. В туысты вирустар антигендік
қасиеттері жағынан табиғи
штамдарға жақын. Олар жаппай ауру
туғызбайды және құстар мен
жануарларды зақымдамайды.
9 слайд
Грипп вирустары — екі туыстасқа бөлінетін (А және В вирустар тобы), ортомиксовирустар тұқымдастығына кіреді. А туыстыққа 14 түрлі гемагглютининдері және 10 түрлі нейраминидазалары бар вируcтар кіреді. В туысты вирустар антигендік қасиеттері жағынан табиғи штамдарға жақын. Олар жаппай ауру туғызбайды және құстар мен жануарларды зақымдамайды.

#10 слайд
10 слайд

#11 слайд
Алдын алу шаралары
Тұмауға нақтылы диагноз қойып, науқасты оқшаулап,
ауруханаларда не басқа тиісті мекемелерде карантин
жарияланады. Тұмауға қарсы вакцина егіледі, оның
ішіндегі ең тиімдісі – тазартылған вириондық вакцина.
Алдын-ала организмді шынықтыратын емдер жасап,
спортпен шұғылданған дұрыс.
Тұмау басталғанда адамның денесі дел-сал болып, көңіл-
күйі нашарлайды және тағамға тәбеті шаппайды.
11 слайд
Алдын алу шаралары Тұмауға нақтылы диагноз қойып, науқасты оқшаулап, ауруханаларда не басқа тиісті мекемелерде карантин жарияланады. Тұмауға қарсы вакцина егіледі, оның ішіндегі ең тиімдісі – тазартылған вириондық вакцина. Алдын-ала организмді шынықтыратын емдер жасап, спортпен шұғылданған дұрыс. Тұмау басталғанда адамның денесі дел-сал болып, көңіл- күйі нашарлайды және тағамға тәбеті шаппайды.

#12 слайд
12 слайд

#13 слайд
Ішек жұқпасы
Жіті ішек жұқпалы аурулары – адамның ағзасына ауыз арқылы
келіп түсетін, әртүрлі бактериялар себебінен орын алатын
жіті ішек инфекцияларының аурулар тобы. Олар дәреттің
бузылуымен қоса, асқазан-ішек жолдарының зақымдалуына
әкеліп соғады.
13 слайд
Ішек жұқпасы Жіті ішек жұқпалы аурулары – адамның ағзасына ауыз арқылы келіп түсетін, әртүрлі бактериялар себебінен орын алатын жіті ішек инфекцияларының аурулар тобы. Олар дәреттің бузылуымен қоса, асқазан-ішек жолдарының зақымдалуына әкеліп соғады.
#14 слайд
Жедел ішек инфекциясы (ЖІИ)– әр түрлі
микроорганизмдер (бактериялар, вирустар,
қарапайымдылар) қоздыратын, клиникалық
белгілері асқазан-ішек жолының әрекетінің
бұзылуымен байқалатын және басқа да белгілері
ұқсас жұқпалы аурулардың тобы.
14 слайд
Жедел ішек инфекциясы (ЖІИ)– әр түрлі микроорганизмдер (бактериялар, вирустар, қарапайымдылар) қоздыратын, клиникалық белгілері асқазан-ішек жолының әрекетінің бұзылуымен байқалатын және басқа да белгілері ұқсас жұқпалы аурулардың тобы.

#15 слайд
Этиологиясы.
Қоздырғыштары - бактериялар (энтеробактерия
тұқымдастар, стафилококтар, вирустар, сирегірек
қарапайымдар).
15 слайд
Этиологиясы. Қоздырғыштары - бактериялар (энтеробактерия тұқымдастар, стафилококтар, вирустар, сирегірек қарапайымдар).

#16 слайд
Бұл топқа вирустар
(энтеровирустар,ротавирус
жұқпасы), бактериялар
(сальмонеллез, дизентерия,холера,
Е.соіі-жұқпасы) арқылы қозатын
және бактерия уытынан
(стафилококтық ішектің уытты
жұқпасында, іштің өтеуінің себебі
бактериялар емес, ас қорыту
жүйесіне стафилококтар өрбіген
тамақ өнімдері арқылы
уыттыңтүсуінен) болатын ішек
жұпалары жатады.
16 слайд
Бұл топқа вирустар (энтеровирустар,ротавирус жұқпасы), бактериялар (сальмонеллез, дизентерия,холера, Е.соіі-жұқпасы) арқылы қозатын және бактерия уытынан (стафилококтық ішектің уытты жұқпасында, іштің өтеуінің себебі бактериялар емес, ас қорыту жүйесіне стафилококтар өрбіген тамақ өнімдері арқылы уыттыңтүсуінен) болатын ішек жұпалары жатады.

#17 слайд
Эпидемиологиясы.
Жұқпаның көзі – қоздырғыштарды
тасымалдайтын ауру адамдар және
жануарлар.
Таралу механизм – нәжіс-ауыз жолы.
Таралужолдары: тамақ арқылы таралу жолы
гастроэнтерит симтомокомплексін
қалыптастырады (тамақ токсикоинфекциясы).
Бір және қысқа мезгілде клиникалық белгілері
ұқсас аурудың күрт көбеюі, ауруханаға
аурулардың көптеп түсуі, аурулардың
жұқтыру қауіпінің аздағымен сипатталады.
17 слайд
Эпидемиологиясы. Жұқпаның көзі – қоздырғыштарды тасымалдайтын ауру адамдар және жануарлар. Таралу механизм – нәжіс-ауыз жолы. Таралужолдары: тамақ арқылы таралу жолы гастроэнтерит симтомокомплексін қалыптастырады (тамақ токсикоинфекциясы). Бір және қысқа мезгілде клиникалық белгілері ұқсас аурудың күрт көбеюі, ауруханаға аурулардың көптеп түсуі, аурулардың жұқтыру қауіпінің аздағымен сипатталады.

#18 слайд
Клиникалық белгілері.
Асқазан – ішек жолының зақымдануы:
-Гастрит (төс шеміршегі астының ауыруы
және қолайсыз сезімінің пайда болуы,
жүректіңайнуы, құсы, кекіру, жүректің
қыжылдауы).
-Энтерит (аурудың бүкіл ішке жайылуы,
іштің кебуі және шұрылдауы, іштің судай
өтуі, шырыш пен қан көп емес).
18 слайд
Клиникалық белгілері. Асқазан – ішек жолының зақымдануы: -Гастрит (төс шеміршегі астының ауыруы және қолайсыз сезімінің пайда болуы, жүректіңайнуы, құсы, кекіру, жүректің қыжылдауы). -Энтерит (аурудың бүкіл ішке жайылуы, іштің кебуі және шұрылдауы, іштің судай өтуі, шырыш пен қан көп емес).

#19 слайд
Антибиотиктерді мақсатсыз және
қадағалаусыз қолдану, ішек дисбактериозын
туғызатын қауіпін дәрігерлер жақсы
түсінулері керек, әсіресе сальмонеллезді және
тамақ уытты жұқпасын емдеген кезде. Жедел
ішек инфекцияларымен ауырған адамдарға ас
қорыту жолдарын қорғайтын
диетатағайындалады. Әдетте №4 диеталық
стол, ал диарея азайғаннан кейін №2 диеталық
стол тағайындалады.
Тамақ уытты жұқпасын емдеген кезде
асқазанды міндетті түрде жуу керек.
19 слайд
Антибиотиктерді мақсатсыз және қадағалаусыз қолдану, ішек дисбактериозын туғызатын қауіпін дәрігерлер жақсы түсінулері керек, әсіресе сальмонеллезді және тамақ уытты жұқпасын емдеген кезде. Жедел ішек инфекцияларымен ауырған адамдарға ас қорыту жолдарын қорғайтын диетатағайындалады. Әдетте №4 диеталық стол, ал диарея азайғаннан кейін №2 диеталық стол тағайындалады. Тамақ уытты жұқпасын емдеген кезде асқазанды міндетті түрде жуу керек.

#20 слайд
Асқынуы:
-Тыныс жүйелерінің және ортаңғы
құлақтың бактериялық
инфекциялары.
-Ішектің дисбактериозы
-Ішектен қан кетуі
-Ішек қабырғасының тесілуі
-Ішектің инвагинациясы
20 слайд
Асқынуы: -Тыныс жүйелерінің және ортаңғы құлақтың бактериялық инфекциялары. -Ішектің дисбактериозы -Ішектен қан кетуі -Ішек қабырғасының тесілуі -Ішектің инвагинациясы

#21 слайд
Алдын алу.
Санитарлы – гигиеналық шараларды
жүргізу, тамақ дайындау технологиясын,
сақтау және тамақ дайындау
технологиясын, сақтау және тамақ
өнімдерін өткізу тәртібін қатал сақтау.
ЖІИ ерте анықтау және ауруды
аңашалау. Жұқпаның ошағында
дезинфекция жүргізу (дезинфекциялық
ертінділермен өңдеу, ыдыстарды
қайнату).
21 слайд
Алдын алу. Санитарлы – гигиеналық шараларды жүргізу, тамақ дайындау технологиясын, сақтау және тамақ дайындау технологиясын, сақтау және тамақ өнімдерін өткізу тәртібін қатал сақтау. ЖІИ ерте анықтау және ауруды аңашалау. Жұқпаның ошағында дезинфекция жүргізу (дезинфекциялық ертінділермен өңдеу, ыдыстарды қайнату).

#22 слайд
Сыртқы қабат жұқпалары
22 слайд
Сыртқы қабат жұқпалары

#23 слайд
Оба
Оба(лат. pestіs – кенеттен басып кіру) – аса
қауіпті зоонозды табиғи ошақты карантиндік
жұқпалы ауру. Обаның өкпелік, ішектік, тері-
бубондық, септикалық түрлері болады.
Себебі Үеrsіnіа реstіs, бактериялық тобына
жататын табиғи - ошақты жұқпалы ауру;
адамға жанасу, ауа - тамшы және
алиментарлық жолмен жұғады, сонымен
қатар тасымалдаушылар - бүргелер арқылы
жұғады карантиндік инфекцияға жатады.
23 слайд
Оба Оба(лат. pestіs – кенеттен басып кіру) – аса қауіпті зоонозды табиғи ошақты карантиндік жұқпалы ауру. Обаның өкпелік, ішектік, тері- бубондық, септикалық түрлері болады. Себебі Үеrsіnіа реstіs, бактериялық тобына жататын табиғи - ошақты жұқпалы ауру; адамға жанасу, ауа - тамшы және алиментарлық жолмен жұғады, сонымен қатар тасымалдаушылар - бүргелер арқылы жұғады карантиндік инфекцияға жатады.

#24 слайд
ТАБИҒАТТА ТҮРЛІ КЕМІРУШІЛЕР АРҚЫЛЫ ТАРАЛАДЫ. АДАМДАРҒА
КЕМІРУШІЛЕРДЕН, НЕ БҮРГЕЛЕРДЕН ЖҰҒАДЫ.
ОБА ТАЯҚШАСЫ (YERSІNІA PESTІS) ПІШІНІ ЖҰМЫРТҚА ТӘРІЗДІ, ҰСАҚ,
ҚОЗҒАЛМАЙДЫ, ТАЛШЫҚТАРЫ БОЛМАЙДЫ, СПОРА ТҮЗБЕЙДІ,
АНИЛИНДІ БОЯҒЫШ ЗАТТАРМЕН ТЕЗ БОЯЛАДЫ. КЕМІРУШІЛЕР
ДЕНЕСІНДЕ 4 – 5 АЙ, БҮРГЕЛЕРДЕ 1 ЖЫЛҒА ДЕЙІН ТІРШІЛІК ЕТЕДІ.
АУРУ ТЕЗ ТАРАЙДЫ. АУРУ ҚОЗДЫРҒЫШЫ САУ АДАМҒА НАУҚАС
АДАМНАН ЖҰҒАДЫ. АУРУДЫҢ ЖАСЫРЫН КЕЗЕҢІ БІРНЕШЕ САҒАТТАН
3 – 6 КҮНГЕ ДЕЙІН СОЗЫЛАДЫ. АУРУ АЯҚ АСТЫНАН БАСТАЛАДЫ,
НАУҚАСТЫҢ ТЕМПЕРАТУРАСЫ 39 – 40°С-ҚА КӨТЕРІЛІП, БАСЫ
АЙНАЛАДЫ. ОРГАНИЗМНІҢ КҮШТІ УЛАНУЫНАН АДАМ ҚҰСЫП, ІШІ
ӨТЕДІ, ЕСІНЕН ТАНЫП, ҮРЕЙ, ҰЙҚЫСЫЗДЫҚ ПАЙДА БОЛАДЫ. АУРУ
АСҚЫНҒАН ЖАҒДАЙДА НАУ-ҚАС ӨЛЕДІ.
24 слайд
ТАБИҒАТТА ТҮРЛІ КЕМІРУШІЛЕР АРҚЫЛЫ ТАРАЛАДЫ. АДАМДАРҒА КЕМІРУШІЛЕРДЕН, НЕ БҮРГЕЛЕРДЕН ЖҰҒАДЫ. ОБА ТАЯҚШАСЫ (YERSІNІA PESTІS) ПІШІНІ ЖҰМЫРТҚА ТӘРІЗДІ, ҰСАҚ, ҚОЗҒАЛМАЙДЫ, ТАЛШЫҚТАРЫ БОЛМАЙДЫ, СПОРА ТҮЗБЕЙДІ, АНИЛИНДІ БОЯҒЫШ ЗАТТАРМЕН ТЕЗ БОЯЛАДЫ. КЕМІРУШІЛЕР ДЕНЕСІНДЕ 4 – 5 АЙ, БҮРГЕЛЕРДЕ 1 ЖЫЛҒА ДЕЙІН ТІРШІЛІК ЕТЕДІ. АУРУ ТЕЗ ТАРАЙДЫ. АУРУ ҚОЗДЫРҒЫШЫ САУ АДАМҒА НАУҚАС АДАМНАН ЖҰҒАДЫ. АУРУДЫҢ ЖАСЫРЫН КЕЗЕҢІ БІРНЕШЕ САҒАТТАН 3 – 6 КҮНГЕ ДЕЙІН СОЗЫЛАДЫ. АУРУ АЯҚ АСТЫНАН БАСТАЛАДЫ, НАУҚАСТЫҢ ТЕМПЕРАТУРАСЫ 39 – 40°С-ҚА КӨТЕРІЛІП, БАСЫ АЙНАЛАДЫ. ОРГАНИЗМНІҢ КҮШТІ УЛАНУЫНАН АДАМ ҚҰСЫП, ІШІ ӨТЕДІ, ЕСІНЕН ТАНЫП, ҮРЕЙ, ҰЙҚЫСЫЗДЫҚ ПАЙДА БОЛАДЫ. АУРУ АСҚЫНҒАН ЖАҒДАЙДА НАУ-ҚАС ӨЛЕДІ.

#25 слайд
25 слайд

#26 слайд
Назарларыңызға рақмет !
26 слайд
Назарларыңызға рақмет !

шағым қалдыра аласыз






 Бұл курс Қазақстан Республикасы Оқу-ағарту министрлігімен келісілген
Бұл курс Қазақстан Республикасы Оқу-ағарту министрлігімен келісілген
